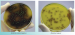

Среда ПАЛ
Питательный агар для выделения листерий сухой
Среда ПАЛ
Для выделения листерий из клинического материала и пищевых продуктов при бактериологических исследованиях.
Данный продукт предназначен для исследовательских целей.
Фасовка 250 г для приготовления 4,4 л среды.
Срок годности 2 года.
- Стерильность: -
- Форма выпуска: Порошок
- Упаковка: 250 г
- Документы: Для исследовательских целей